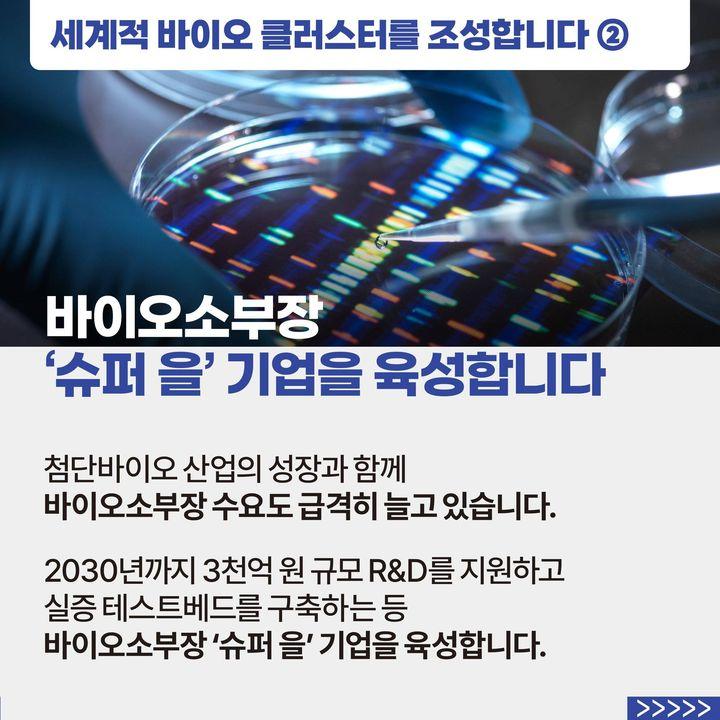

미래를 바꿀 ‘게임체인저’ 첨단바이오 기술이 새로운 성장동력이 되도록 적극 지원하겠습니다.
∨ 첨단바이오 이니셔티브 발표
∨ k-바이오 스퀘어 조성
∨ 바이오소부장 '슈퍼 을' 기업 육성
■ 첨단바이오 선도국으로 도약합니다.
AI 활용 신약개발, AI 의료기기 등 첨단바이오 산업을 키웁니다.
전통 바이오에 AI 등 디지털을 융합한 첨단바이오 선도국으로 도약하기 위해 첨단바이오 이니셔티브를 발표할 것입니다.
‘게임체인저’ 첨단바이오에 R&D 투자를 늘려 반도체에 이은 차세대 주력산업으로 만들고 2035년까지 200조 원 시대를 열겠습니다.
■ 세계적 바이오 클러스터를 조성합니다.
기반시설, 인재가 모인 K-바이오 스퀘어를 만듭니다.
‘국내 바이오 대표’ 오송 바이오클러스터를 교육·연구기관 기업, 병원 등이 입주하는 세계적인 첨단바이오 클러스터로 혁신합니다.
근처에 KAIST 캠퍼스를 조성하고 2027년 개교할 AI BIO 과학영재학교와 연계해 인재 양성 거점으로 육성합니다.
바이오소부장 ‘슈퍼 을’ 기업을 육성합니다.
첨단바이오 산업의 성장과 함께 바이오소부장 수요도 급격히 늘고 있습니다.
2030년까지 3천억 원 규모 R&D를 지원하고 실증 테스트베드를 구축하는 등 바이오소부장 ‘슈퍼 을’ 기업을 육성합니다.
미래를 바꿀 ‘게임체인저’ 첨단바이오 기술이 새로운 성장동력이 되도록 적극 지원하겠습니다.
☞ 자세히 보기
[국민과 함께하는 스물네 번째 민생토론회] R&D 투자 확대, 바이오소부장 기업 육성
미래를 바꿀 ‘게임체인저’ 첨단바이오 기술이 새로운 성장동력이 되도록 적극 지원하겠습니다.
∨ 첨단바이오 이니셔티브 발표
∨ k-바이오 스퀘어 조성
∨ 바이오소부장 '슈퍼 을' 기업 육성
■ 첨단바이오 선도국으로 도약합니다.
AI 활용 신약개발, AI 의료기기 등 첨단바이오 산업을 키웁니다.
전통 바이오에 AI 등 디지털을 융합한 첨단바이오 선도국으로 도약하기 위해 첨단바이오 이니셔티브를 발표할 것입니다.
‘게임체인저’ 첨단바이오에 R&D 투자를 늘려 반도체에 이은 차세대 주력산업으로 만들고 2035년까지 200조 원 시대를 열겠습니다.
■ 세계적 바이오 클러스터를 조성합니다.
기반시설, 인재가 모인 K-바이오 스퀘어를 만듭니다.
‘국내 바이오 대표’ 오송 바이오클러스터를 교육·연구기관 기업, 병원 등이 입주하는 세계적인 첨단바이오 클러스터로 혁신합니다.
근처에 KAIST 캠퍼스를 조성하고 2027년 개교할 AI BIO 과학영재학교와 연계해 인재 양성 거점으로 육성합니다.
바이오소부장 ‘슈퍼 을’ 기업을 육성합니다.
첨단바이오 산업의 성장과 함께 바이오소부장 수요도 급격히 늘고 있습니다.
2030년까지 3천억 원 규모 R&D를 지원하고 실증 테스트베드를 구축하는 등 바이오소부장 ‘슈퍼 을’ 기업을 육성합니다.
미래를 바꿀 ‘게임체인저’ 첨단바이오 기술이 새로운 성장동력이 되도록 적극 지원하겠습니다.
☞ 자세히 보기
 이 누리집은 대한민국 공식 전자정부 누리집입니다.
이 누리집은 대한민국 공식 전자정부 누리집입니다.